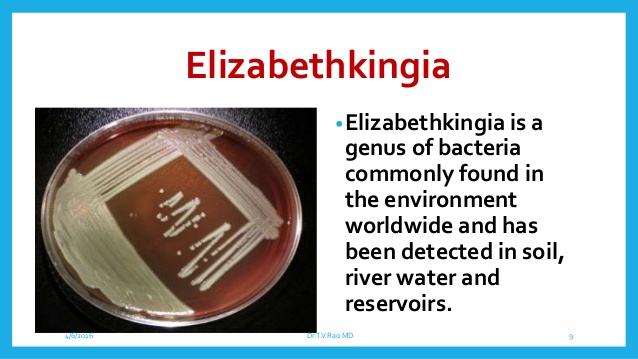

Bệnh truyền nhiễm gây ra bởi các tác nhân vi sinh vật như vi khuẩn, virus, ký sinh trùng và vi nấm. Bệnh có thể lan rộng theo con đường trực tiếp hoặc gián tiếp sang động vật và người khác. Các bệnh lây truyền từ động vật sang người cũng là các bệnh truyền nhiễm, hiện nay có ít nhất 217 căn bệnh truyền nhiễm được liệt kê vào danh sách các bệnh truyền nhiễm ghi nhận trên phạm vi toàn cầu.
Trong số 5 bệnh truyền nhiễm cảnh báo năm 2017 có 4 bệnh là do vector truyền
Với diễn tiến của quá trình biến đổi khí hậu, thay đổi sinh thái và áp lực dân số đã góp phần làm cho các bệnh truyền nhiễm truyền từ động vật sang người hoặc từ người sang động vật (zoonosis/zoonose) gia tăng trong thời gian vừa qua. Trong năm 2017, giới chuyên gia về bệnh truyền nhiễm đưa ra cảnh báo về 5 bệnh truyền nhiễm cần lưu ý trong năm 2017, trong số đó có 4/5 bệnh là bệnh do vector truyền nguy hiểm.

Hình 1
- Bệnh Leishmaniasis
Đây là một bệnh do nhiễm ký sinh trùng đơn bào Leishmania spp., một tác nhân đơn bào thuộc lớp trùng roi, sống ký sinh trong tế bào của hệ võng mô, gây nhiễm bệnh cho con người qua trung gian truyền bệnh là muỗi cát phlebotomus - một loài muỗi rất nhỏ, kích thước khoảng 3mm, chỉ muỗi cái hút máu ký chủ và đốt rất đau. Muỗi đốt người cả trong và ngoài nhà, thời gian hoạt động chủ yếu là từ lúc chiều tối đến sáng hôm sau. Bệnh gặp ở hơn 90 quốc gia vùng nhiệt đới, cận nhiệt đới và miền nam châu Âu, thường phổ biến ở nông thôn hơn thành thị.Ở Việt Nam đã từng phát hiện 3 bệnh nhân mắc bệnh này tại Quảng Ninh vào năm 2001.
Bệnh Leishmaniasis được xem như là một bệnh nhiệt đới đang bị lãng quên nhưng gần đây lại được chú ý sau khi xuất hiện tại châu Âu do làn sóng di cư của người tị nạn Syria. Khi bị muỗi cát mang ký sinh trùng Leishmania spp. đốt, người lành sẽ bị truyền ký sinh trùng và mắc bệnh Leishmaniasis. Ở người, có nhiều hình thức khác nhau của bệnh Leishmaniasis, phổ biến nhất là Leishmaniasis da, gây lở loét da và Leishmaniasis nội tạng làm ảnh hưởng đến nhiều cơ quan nội tạng (thường là lách, gan và tủy xương), có thể đe dọa tính mạng bệnh nhân.
Bệnh thường phát triển trong vòng nhiều tháng (đôi khi nhiều năm) sau khi muỗi cát đốt. Đặc trưng bởi những cơn sốt bất thường, sụt cân, gan to, lách to và thiếu máu... Ở một số nơi, các loài động vật bị bệnh như các loài gặm nhấm, chó… duy trì nguồn lây nhiễm trong tự nhiên.
Tuy nhiên, ở một số nơi trên thế giới, người bệnh là nguồn lây chủ yếu. Đây là hình thức lây truyền người - muỗi - người, ở những vùng này, điều trị triệt để các bệnh nhân có thể giúp kiểm soát sự lây lan của ký sinh trùng. (Chi tiết về căn bệnh này sẽ có bài chi tiết số tiếp theo trên cùng trang website http://www.impe-qn.org.vn)
- Sốt thung lũng Rift
Đây là bệnh lây lan do Phlebovirus, thuộc họ Bunyaviridae qua muỗi truyền nhưng không truyền từ người này sang người khác. Có rất nhiều loài muỗi khác nhau như Aedes spp., Anopheles spp., Culex spp., Eretmapodites spp., Mansonia spp.... có thể đóng vai trò trung gian truyền bệnh. Vì vậy, nguy cơ dịch bệnh xuất hiện ở những nơi có mặt của những loài muỗi này rất phổ biến.

Hình 2
Đặc biệt, loài muỗi Aedes spp. có thể nhiễm virus do đốt máu gia súc bị bệnh, sau đó nó có thể truyền virus qua trứng và trứng của loại muỗi này có khả năng tồn tại vài năm trong điều kiện thời tiết khô ráo, chờ đến mùa mưa sẽ nở thành muỗi con mang mầm bệnh. Chính vì đặc điểm này, virut có thể tồn tại lâu dài trong tự nhiên và gây khó khăn cho việc loại trừ nguồn gây bệnh. Ngoài ra, virus có thể xâm nhập vào cơ thể con người để gây bệnh qua các vết thương hở nếu người tiếp xúc trực tiếp với gia súc và sản phẩm của gia súc bị bệnh như thịt, máu, dịch thể, nội tạng hoặc uống sữa tươi có mầm bệnh chưa được tiệt trùng hay hít phải mầm bệnh virut bay lơ lửng ngoài không khí.
Khi mắc bệnh này, biểu hiện ban đầu thường nhầm lẫn với bệnh cúm với dấu hiệu sốt đột ngột, đau đầu, đau cơ, đau lưng.Bệnh sốt thung lũng Riff có tiến triển gây xuất huyết nội, suy gan, viêm não và mù lòa. Tỷ lệ tử vong do bệnh chỉ là 1% nhưng lại tăng lên đến 50% nếu chảy máu xảy ra.

Hình 3
- Sốt Oropouche
Virus Oropouche được truyền sang người do nhóm muỗi Culex spp. đốt với phạm vi phân bố còn rộng hơn muỗi Acedes spp. gây bệnh Zika hay muỗi cát làm lây lan bệnh Leishmaniasis. Điều này gây mối lo ngại về sự lan tràn dịch sốt Oropouche từ vùng Amazon sang Nam Mỹ. Virus Oropouche thường gây sốt kèm theo hiện tượng chán ăn, đau đầu, nôn mửa. Biến chứng thường gặp và đáng lo ngại nhất của bệnh này là viêm màng não.
Sốt do virus Oropouche do virus Oropouche ở người lây truyền đầu tiên qua muỗi thuộc Culicoides paraensis. Không có lây truyền trực tiếp từ người sang người. Sốt do Oropouche virus có triệu chứng sốt như hội chứng khi nhiễm virus Dengue với thời gian ủ bệnh 4-8 ngày (dao động 3-12 ngày). Các triệu chứng gồm có khởi phát sốt cao đột ngột kèm theo các triệu chứng nhức đầu, đau cơ, nôn mửa, đau khớp. Trên một số bệnh nhân có các triệu chứng lâm sàng như một viêm màng não vô trùng. Tại vùng châu Mỹ, các vụ dịch sốt do virus Oropouche đã được ghi nhận và báo cáo tại các vùng nông thôn và đô thị ở Brazil, Ecuador, Panama, Peru và Trinidad, Tobago.
- Sốt Mayaro
Khi mắc bệnh này, người bệnh thường có dấu hiệu đặc trưng là sốt, đau nhức và phát ban. Đây là bệnh do muỗi Aedes spp. truyền và là họ hàng xa của sốt Chikungunya - một loại bệnh do virut thuộc giống Alphavirus, họ Togaviridae, được truyền từ người này sang người khác thông qua vết đốt của muỗi Aedes spp., chủ yếu do loài muỗi Aedes aegypti và Aedes albopictus và cả hai loài muỗi này hoạt động vào ban ngày.
Virus Mayaro chủ yếu lây truyền qua muỗi Hamagogus nhưng muỗi Aedes aegypti, loài muỗi truyền virus Zika, cũng có thể là vật chủ mang virus này. Virus Mayaro được phát hiện đầu tiên ở Trinidad vào năm 1954. Sau đó, nó đã lan tới Guinea thuộc Pháp, Venezuela, Peru, Bolivia và Brazil thuộc châu Mỹ. Hiện thông tin về virus Mayaro rất ít nhưng gần đây, bệnh bất ngờ xuất hiện tại Haiti do sự xuống cấp của cơ sở y tế vốn đã thiếu thốn của nước này bởi trận động đất năm 2010. Điều này cho thấy những bệnh mới nổi có xu hướng phát triển ở những nơi có chiến tranh xảy ra, vệ sinh kém, nghèo đói và thiếu thốn.

Hình 4
- Elizabethkingia
Elizabethkingia là một giống vi khuẩn thường tìm thấy trong môi trường trên phạm vi toàn cầu và đặc biệt đã phát hiện ở trong đất, nước sông, ổ chứa khác. Tuy nhiên, hiếm người mắc bệnh và trở nên đau. Các ca được chẩn đoán thông qua xét nghiệm nuôi cấy các dịch và máu. Elizabethkingia thường gây ra viêm màng não ở trên các trẻ sơ sinh và có thể đi vào dòng máu gây viêm hô hấp ở người suy giảm miễn dịch. Khoảng chứng 5-10 ca ở mỗi bang mỗi năm của Mỹ và một số ca báo cáo rải rác trong vụ dịch ở Mỹ và các quốc gia khác.
Đây là một chi của vi khuẩn được mô tả vào năm 2005, được đặt theo tên của nhà vi trùng học người Mỹ Elizabeth Osborne King, người phát hiện ra các loài vi khuẩn điển hình, có mặt ở khắp nơi trên thế giới và gây ra những dạng viêm nặng như viêm màng não, viêm phổi, nhiễm khuẩn huyết.
Hình 5
Một nghiên cứu năm 2014 cho thấy Elizabethkingia là một vi khuẩn gây bệnh mới nổi trong môi trường bệnh viện, với tỷ lệ hiện diện của chúng trong các đơn vị chăm sóc đặc biệt đã tăng lên đáng kể từ năm 2004. Chúng sở hữu bộ gene có khả năng kháng kháng sinh và có độc lực.
Với một phác đồ điều trị kém hiệu quả thì có thể dẫn đến tỷ lệ tử vong cao cho bệnh nhân. Đây cũng là tác nhân gây bệnh duy nhất không phải do virut trong danh sách bệnh truyền nhiễm này nhưng nó là nguyên nhân gây ra sự gia tăng các trường hợp bệnh trong một thế giới nơi mà kháng sinh không còn là chỗ dựa để cứu mạng sống của con người khỏi nhiễm khuẩn.
Dịch bệnh truyền nhiễm năm 2017 sẽ tiếp tục diễn biến phức tạp
Theo Cục trưởng Cục Y tế dự phòng PGS.TS. Trần Đắc Phu cho biết, năm 2017, tình hình dịch bệnh tiếp tục diễn biến phức tạp do nhiều nguyên nhân như sự giao lưu đi lại của người dân giữa các quốc gia, đô thị hóa rõ nét, biến đổi khí hậu và tập quán của người dân. Đặc biệt, thời tiết mùa Đông –Xuân hiện nay là điều kiện thuận lợi cho nhiều dịch bệnh có nguy cơ bùng phát như bệnh sốt xuất huyết, Zika, cúm gia cầm, tay chân miệng... Do đó, công tác phòng, chống, kiểm soát dịch bệnh cần được các đơn vị y tế chú trọng. Thời gian tới, ngành y tế sẽ triển khai quyết liệt công tác kiểm soát dịch bệnh, tăng cường các hoạt động giám sát tại khu vực cửa khẩu, cộng đồng; phối hợp với các cơ sở khám chữa bệnh để nắm chắc tình hình bệnh nhân mắc bệnh truyền nhiễm nhập viện trong dịp Tết Nguyên đán và trong mùa lễ hội đầu năm để phát hiện sớm các ổ dịch và xử lý kịp thời.

Hình 6
Ngành y tế tiếp tục thực hiện việc giám sát trọng điểm cúm và hội chứng viêm phổi cấp để phát hiện sớm các trường hợp bệnh nghi ngờ; chủ động triển khai các biện pháp phòng chống dịch bệnh trong các cơ sở y tế; phối hợp với Chi Cục Thú y thuộc Sở Nông nghiệp và Phát triển nông thôn để chia sẻ thông tin và triển khai các hoạt động phòng chống dịch bệnh lây truyền từ động vật sang người. Người dân cần thực hiện các biện pháp vệ sinh môi trường khu vực sinh sống, tạo môi trường làm việc xanh, sạch, đẹp; giữ vệ sinh cá nhân phù hợp để chu động phòng, chống, kiểm soát dịch bệnh, không để bệnh lây lan.
Năm 2016, Việt Nam ghi nhận 110.876 trường hợp mắc SXH, trong đó có 36 trường hợp tử vong. Về bệnh do vi rút Zika, tại Việt Nam, số trường hợp nhiễm vi rút Zika là 212 trường hợp tại 11 tỉnh, thành phố. Trong đó TP. Hồ Chí Minh có số trường hợp mắc nhiều nhất; khu vực miền Bắc chưa ghi nhận trường hợp nào. Với bệnh tay chân miệng, năm 2016, Việt Nam ghi nhận 50.032 trường hợp mắc bệnh tay chân miệng. Trong đó có 1 trường hơp tử vong. Đối với bệnh cúm, năm 2016, nước ta ghi nhận lưu hành của cúm A và cúm B, trong đó cúm A(H3) chiếm ưu thế. Cụ thể: cúm A(H3) chiếm 46,1%, cúm B chiếm 35,8%, cúm A(H1N1) chiếm 18,2%... Đặc biệt, Việt Nam chưa ghi nhận trường hợp mắc cúm A(H5N1), cúm A(H7N9) và cúm A(H5N6). |
Chủ động kiểm soát tốt dịch bệnh truyền nhiễm vào Việt Nam
Cúm gia cầm, Ebola, MERS-CoV,… đang có diễn biến rất phức tạp. Do sự giao lưu thương mại, du lịch, lao động mạnh mẽ giữa các khu vực khiến mầm bệnh có thể dễ dàng bị phát tán, trở thành nguy cơ đối với cả những quốc gia vẫn đang ngoài vùng dịch. Đó là thông tin vừa được PGS.TS Trần Đắc Phu, Cục trưởng Cục Y tế dự phòng (Bộ Y tế) cho biết tại Hội nghị Tăng cường công tác phòng chống dịch khu vực phía Nam diễn ra tại TP. Hồ Chí Minh sáng ngày 16-2.
Cục trưởng Cục Y tế dự phòng Trần Đắc Phu cảnh báo, tình hình dịch bệnh trên thế giới như: Cúm gia cầm, ebola, MERS-CoV đang có diễn biến rất phức tạp. Do sự giao lưu thương mại, du lịch, lao động mạnh mẽ giữa các khu vực khiến mầm bệnh có thể dễ dàng bị phát tán, trở thành nguy cơ đối với cả những quốc gia vẫn đang ngoài vùng dịch. Nếu không thực hiện tốt các biện pháp kiểm soát và ngăn chặn, các dịch bệnh đang lưu hành và dịch bệnh mới có thể xâm nhập, bùng phát ở Việt Nam trong năm 2017.
Tại Việt Nam, một số bệnh dịch lưu hành như SXH, tay chân miệng, Zika, dại, nhiễm liên cầu lợn, viêm não vi rút vẫn là thách thức lớn đối với việc giảm số mắc và tử vong. Theo PGS. TS Trần Đắc Phu, năm 2016 cả nước ghi nhận 91 trường hợp tử vong do bệnh dại, tăng 13 trường hợp so với năm 2015. Đáng chú ý, các trường hợp mắc bệnh dại tập trung chủ yếu tại một số tỉnh phía Bắc. Đa số các trường hợp tử vong do không đi tiêm phòng dại.
Nhiều người không đi tiêm phòng vaccine sau khi bị chó cắn vì chủ quan, hoặc điều trị bằng thuốc nam và không ít người không tiêm do không hiểu biết về bệnh dại. Ngoài ra, nguyên nhân tử vong do bệnh dại vẫn ở mức cao là do tỷ lệ tiêm phòng cho đàn chó đạt thấp. Đồng thời, năm 2016, cả nước cũng ghi nhận 90 trường hợp mắc liên cầu lợn làm 7 trường hợp tử vong. Mặc dù số ca mắc và tử vong đều giảm so với năm 2015, nhưng vẫn đáng cảnh báo vì đa số các trường hợp mắc là do ăn tiết canh sống.
Theo PGS.TS Trần Đắc Phu, kể cả với các bệnh có vaccine phòng bệnh vẫn ghi nhận rải rác các trường hợp mắc bệnh. Không loại trừ khả năng có thể xảy ra các ổ dịch tại “vùng lõm” có tỉ lệ tiêm chủng chưa cao và không quản lý tốt đối tượng tiêm chủng. Ngoài ra, hiện nay một số bệnh chưa được người dân quan tâm như bệnh do ký sinh trùng đơn bào, viêm gan vi rút vẫn ghi nhận, song chưa được quan tâm đầu tư.

Hình 7
PGS.TS. Phan Trọng Lân, Viện trưởng Viện Pasteur TP. Hồ Chí Minh cho biết Tổ chức Y tế thế giới đánh giá Zika vẫn là thách thức lâu dài, đòi hỏi thiết lập kế hoạch đáp ứng dài hạn, liên tục, đặc biệt là trong bối cảnh tần suất giao lưu đi lại cao, biến động dân cư mạnh. Tại Việt Nam, dự báo năm 2017 gia tăng bệnh do virus Zika tại tất cả tỉnh khu vực phía Nam. Đây là khu vực thuộc vùng lưu hành của muỗi vằn, ổ bọ gầy nguồn đa dạng, phong phú, đòi hỏi có kế hoạch giám soát và ứng phó, xử lý triệt để các ổ dịch ngay từ đầu. PGS.TS Trần Đắc Phu khuyến cáo để phòng, chống dịch bệnh hiệu quả, năm 2017, ngành Y tế cần tiếp tục tăng cường hệ thống giám sát thường xuyên tại cửa khẩu, cơ sở y tế và cộng đồng.
Đảm bảo phát hiện sớm ca bệnh đầu tiên, báo cáo kịp thời; triển khai giám sát trọng điểm bệnh cúm, sốt xuất huyết, tay chân miệng, viêm não Nhật Bản, zika. Bên cạnh đó, chú trọng đến công tác tập huấn kỹ năng giám sát phát hiện, chẩn đoán một số bệnh.
Tên bệnh hoặc Hội chứng nhiễm trùng | Nguồn bệnh |
Acinetobacter infections | Acinetobacter baumannii |
Actinomycosis | Actinomyces israelii, Actinomyces gerencseriae and Propionibacterium propionicus |
African sleeping sickness (African trypanosomiasis) | Trypanosoma brucei |
AIDS (Acquired immunodeficiency syndrome) | HIV (Human immunodeficiency virus) |
Amebiasis | Entamoeba histolytica |
Anaplasmosis | Anaplasma species |
Angiostrongyliasis | Angiostrongylus |
Anisakiasis | Anisakis |
Anthrax | Bacillus anthracis |
Arcanobacterium haemolyticum infection | Arcanobacterium haemolyticum |
Argentine hemorrhagic fever | Junin virus |
Ascariasis | Ascaris lumbricoides |
Aspergillosis | Aspergillus species |
Astrovirus infection | Astroviridae family |
Babesiosis | Babesia species |
Bacillus cereus infection | Bacillus cereus |
Bacterial pneumonia | multiple bacteria |
Bacterial vaginosis | List of bacterial vaginosis microbiota |
Bacteroides infection | Bacteroides species |
Balantidiasis | Balantidium coli |
Bartonellosis | Bartonella |
Baylisascaris infection | Baylisascaris species |
BK virus infection | BK virus |
Black piedra | Piedraia hortae |
Blastocystosis | Blastocystis species |
Blastomycosis | Blastomyces dermatitidis |
Bolivian hemorrhagic fever | Machupo virus |
Botulism (and Infant botulism) | Clostridium botulinum; Note: Botulism is not an infection by Clostridium botulinum but caused by the intake of botulinum toxin. |
Brazilian hemorrhagic fever | Sabiá virus |
Brucellosis | Brucella species |
Bubonic plague | the bacterial family Enterobacteriaceae |
Burkholderia infection | usually Burkholderia cepacia and other Burkholderia species |
Buruli ulcer | Mycobacterium ulcerans |
Calicivirus infection (Norovirus and Sapovirus) | Caliciviridae family |
Campylobacteriosis | Campylobacter species |
Candidiasis (Moniliasis; Thrush) | usually Candida albicans and other Candida species |
Capillariasis | Intestinal disease by Capillaria philippinensis, hepatic disease by Capillaria hepatica and pulmonary disease by Capillaria aerophila |
Carrion´s disease | Bartonella bacilliformis |
Cat-scratch disease | Bartonella henselae |
Cellulitis | usually Group A Streptococcus and Staphylococcus |
Chagas Disease (American trypanosomiasis) | Trypanosoma cruzi |
Chancroid | Haemophilus ducreyi |
Chickenpox | Varicella zoster virus (VZV) |
Chikungunya | Alphavirus |
Chlamydia | Chlamydia trachomatis |
Chlamydophila pneumoniae infection (Taiwan acute respiratory agent or TWAR) | Chlamydophila pneumoniae |
Cholera | Vibrio cholerae |
Chromoblastomycosis | usually Fonsecaea pedrosoi |
Chytridiomycosis | Batrachochytrium dendrabatidis |
Clonorchiasis | Clonorchis sinensis |
Clostridium difficile colitis | Clostridium difficile |
Coccidioidomycosis | Coccidioides immitis and Coccidioides posadasii |
Colorado tick fever (CTF) | Colorado tick fever virus (CTFV) |
Common cold (Acute viral rhinopharyngitis; Acute coryza) | usually rhinoviruses and coronaviruses |
Creutzfeldt–Jakob disease (CJD) | PRNP |
Crimean-Congo hemorrhagic fever (CCHF) | Crimean-Congo hemorrhagic fever virus |
Cryptococcosis | Cryptococcus neoformans |
Cryptosporidiosis | Cryptosporidium species |
Cutaneous larva migrans (CLM) | usually Ancylostoma braziliense; multiple other parasites |
Cyclosporiasis | Cyclospora cayetanensis |
Cysticercosis | Taenia solium |
Cytomegalovirus infection | Cytomegalovirus |
Dengue fever | Dengue viruses (DEN-1, DEN-2, DEN-3 and DEN-4) – Flaviviruses |
Desmodesmus infection | Green algae Desmodesmus armatus |
Dientamoebiasis | Dientamoeba fragilis |
Diphtheria | Corynebacterium diphtheriae |
Diphyllobothriasis | Diphyllobothrium |
Dracunculiasis | Dracunculus medinensis |
Ebola hemorrhagic fever | Ebolavirus (EBOV) |
Echinococcosis | Echinococcus species |
Ehrlichiosis | Ehrlichia species |
Enterobiasis (Pinworm infection) | Enterobius vermicularis |
Enterococcus infection | Enterococcus species |
Enterovirus infection | Enterovirus species |
Epidemic typhus | Rickettsia prowazekii |
Erythema infectiosum (Fifth disease) | Parvovirus B19 |
Exanthem subitum (Sixth disease) | Human herpesvirus 6 (HHV-6) and Human herpesvirus 7 (HHV-7) |
Fasciolasis | Fasciola hepatica and Fasciola gigantica |
Fasciolopsiasis | Fasciolopsis buski |
Fatal familial insomnia (FFI) | PRNP |
Filariasis | Filarioidea superfamily |
Food poisoning by Clostridium perfringens | Clostridium perfringens |
Free-living amebic infection | multiple |
Fusobacterium infection | Fusobacterium species |
Gas gangrene (Clostridial myonecrosis) | usually Clostridium perfringens; other Clostridium species |
Geotrichosis | Geotrichum candidum |
Gerstmann-Sträussler-Scheinker syndrome (GSS) | PRNP |
Giardiasis | Giardia lamblia |
Glanders | Burkholderia mallei |
Gnathostomiasis | Gnathostoma spinigerum and Gnathostoma hispidum |
Gonorrhea | Neisseria gonorrhoeae |
Granuloma inguinale (Donovanosis) | Klebsiella granulomatis |
Group A streptococcal infection | Streptococcus pyogenes |
Group B streptococcal infection | Streptococcus agalactiae |
Haemophilus influenzae infection | Haemophilus influenzae |
Hand, foot and mouth disease (HFMD) | Enteroviruses, mainly Coxsackie A virus and Enterovirus 71 (EV71) |
Hantavirus Pulmonary Syndrome (HPS) | Sin Nombre virus |
Heartland virus disease | Heartland virus |
Helicobacter pylori infection | Helicobacter pylori |
Hemolytic-uremic syndrome (HUS) | Escherichia coli O157:H7, O111 and O104:H4 |
Hemorrhagic fever with renal syndrome (HFRS) | Bunyaviridae family |
Hepatitis A | Hepatitis A virus |
Hepatitis B | Hepatitis B virus |
Hepatitis C | Hepatitis C virus |
Hepatitis D | Hepatitis D Virus |
Hepatitis E | Hepatitis E virus |
Herpes simplex | Herpes simplex virus 1 and 2 (HSV-1 and HSV-2) |
Histoplasmosis | Histoplasma capsulatum |
Hookworm infection | Ancylostoma duodenale and Necator americanus |
Human bocavirus infection | Human bocavirus (HBoV) |
Human ewingii ehrlichiosis | Ehrlichia ewingii |
Human granulocytic anaplasmosis (HGA) | Anaplasma phagocytophilum |
Human metapneumovirus infection | Human metapneumovirus (hMPV) |
Human monocytic ehrlichiosis | Ehrlichia chaffeensis |
Human papillomavirus (HPV) infection | Human papillomavirus (HPV) |
Human parainfluenza virus infection | Human parainfluenza viruses (HPIV) |
Hymenolepiasis | Hymenolepis nana and Hymenolepis diminuta |
Epstein–Barr virus infectious mononucleosis (Mono) | Epstein–Barr virus (EBV) |
Influenza (flu) | Orthomyxoviridae family |
Isosporiasis | Isospora belli |
Kawasaki disease | unknown; evidence supports that it is infectious |
Keratitis | multiple |
Kingella kingae infection | Kingella kingae |
Kuru | PRNP |
Lassa fever | Lassa virus |
Legionellosis (Legionnaires' disease) | Legionella pneumophila |
Legionellosis (Pontiac fever) | Legionella pneumophila |
Leishmaniasis | Leishmania species |
Leprosy | Mycobacterium leprae and Mycobacterium lepromatosis |
Leptospirosis | Leptospira species |
Listeriosis | Listeria monocytogenes |
Lyme disease (Lyme borreliosis) | Borrelia burgdorferi, Borrelia garinii, and Borrelia afzelii |
Lymphatic filariasis (Elephantiasis) | Wuchereria bancrofti and Brugia malayi |
Lymphocytic choriomeningitis | Lymphocytic choriomeningitis virus (LCMV) |
Malaria | Plasmodium species |
Marburg hemorrhagic fever (MHF) | Marburg virus |
Measles | Measles virus |
Middle East respiratory syndrome (MERS) | Middle East respiratory syndrome coronavirus |
Melioidosis (Whitmore's disease) | Burkholderia pseudomallei |
Meningitis | multiple |
Meningococcal disease | Neisseria meningitidis |
Metagonimiasis | usually Metagonimus yokagawai |
Microsporidiosis | Microsporidia phylum |
Molluscum contagiosum (MC) | Molluscum contagiosum virus (MCV) |
Monkeypox | Monkeypox virus |
Mumps | Mumps virus |
Murine typhus (Endemic typhus) | Rickettsia typhi |
Mycoplasma pneumonia | Mycoplasma pneumoniae |
Mycetoma (disambiguation) | numerous species of bacteria (Actinomycetoma) and fungi (Eumycetoma) |
Myiasis | parasitic dipterous fly larvae |
Neonatal conjunctivitis (Ophthalmia neonatorum) | most commonly Chlamydia trachomatis and Neisseria gonorrhoeae |
Norovirus (children and babies) | (New) Variant Creutzfeldt–Jakob disease (vCJD, nvCJD) |
Nocardiosis | usually Nocardia asteroides and other Nocardia species |
Onchocerciasis (River blindness) | Onchocerca volvulus |
Opisthorchiasis | Opisthorchis viverrini and Opisthorchis felineus |
Paracoccidioidomycosis (South American blastomycosis) | Paracoccidioides brasiliensis |
Paragonimiasis | usually Paragonimus westermani and other Paragonimus species |
Pasteurellosis | Pasteurella species |
Pediculosis capitis (Head lice) | Pediculus humanus capitis |
Pediculosis corporis (Body lice) | Pediculus humanus corporis |
Pediculosis pubis (Pubic lice, Crab lice) | Phthirus pubis |
Pelvic inflammatory disease (PID) | multiple |
Pertussis (Whooping cough) | Bordetella pertussis |
Plague | Yersinia pestis |
Pneumococcal infection | Streptococcus pneumoniae |
Pneumocystis pneumonia (PCP) | Pneumocystis jirovecii |
Pneumonia | multiple |
Poliomyelitis | Poliovirus |
Prevotella infection | Prevotella species |
Primary amoebic meningoencephalitis (PAM) | usually Naegleria fowleri |
Progressive multifocal leukoencephalopathy | JC virus |
Psittacosis | Chlamydophila psittaci |
Q fever | Coxiella burnetii |
Rabies | Rabies virus |
Relapsing fever | Borrelia hermsii, Borrelia recurrentis, and other Borrelia species |
Respiratory syncytial virus infection | Respiratory syncytial virus (RSV) |
Rhinosporidiosis | Rhinosporidium seeberi |
Rhinovirus infection | Rhinovirus |
Rickettsial infection | Rickettsia species |
Rickettsialpox | Rickettsia akari |
Rift Valley fever (RVF) | Rift Valley fever virus |
Rocky Mountain spotted fever (RMSF) | Rickettsia rickettsii |
Rotavirus infection | Rotavirus |
Rubella | Rubella virus |
Salmonellosis | Salmonella species |
SARS (Severe Acute Respiratory Syndrome) | SARS coronavirus |
Scabies | Sarcoptes scabiei |
Schistosomiasis | Schistosoma species |
Sepsis | multiple |
Shigellosis (Bacillary dysentery) | Shigella species |
Shingles (Herpes zoster) | Varicella zoster virus (VZV) |
Smallpox (Variola) | Variola major or Variola minor |
Sporotrichosis | Sporothrix schenckii |
Staphylococcal food poisoning | Staphylococcus species |
Staphylococcal infection | Staphylococcus species |
Strongyloidiasis | Strongyloides stercoralis |
Subacute sclerosing panencephalitis | Measles virus |
Syphilis | Treponema pallidum |
Taeniasis | Taenia species |
Tetanus (Lockjaw) | Clostridium tetani |
Tinea barbae (Barber's itch) | usually Trichophyton species |
Tinea capitis (Ringworm of the Scalp) | usually Trichophyton tonsurans |
Tinea corporis (Ringworm of the Body) | usually Trichophyton species |
Tinea cruris (Jock itch) | usually Epidermophyton floccosum, Trichophyton rubrum, and Trichophyton mentagrophytes |
Tinea manum (Ringworm of the Hand) | Trichophyton rubrum |
Tinea nigra | usually Hortaea werneckii |
Tinea pedis (Athlete’s foot) | usually Trichophyton species |
Tinea unguium (Onychomycosis) | usually Trichophyton species |
Tinea versicolor (Pityriasis versicolor) | Malassezia species |
Toxocariasis (Ocular Larva Migrans (OLM)) | Toxocara canis or Toxocara cati |
Toxocariasis (Visceral Larva Migrans (VLM)) | Toxocara canis or Toxocara cati |
Trachoma | Chlamydia trachomatis |
Toxoplasmosis | Toxoplasma gondii |
Trichinosis | Trichinella spiralis |
Trichomoniasis | Trichomonas vaginalis |
Trichuriasis (Whipworm infection) | Trichuris trichiura |
Tuberculosis | usually Mycobacterium tuberculosis |
Tularemia | Francisella tularensis |
Typhoid fever | Salmonella enterica subsp. enterica, serovar typhi |
Typhus fever | Rickettsia |
Ureaplasma urealyticum infection | Ureaplasma urealyticum |
Valley fever | Coccidioides immitis or Coccidioides posadasii.[1] |
Venezuelan equine encephalitis | Venezuelan equine encephalitis virus |
Venezuelan hemorrhagic fever | Guanarito virus |
Vibrio vulnificus infection | Vibrio vulnificus |
Vibrio parahaemolyticus enteritis | Vibrio parahaemolyticus |
Viral pneumonia | multiple viruses |
West Nile Fever | West Nile virus |
White piedra (Tinea blanca) | Trichosporon beigelii |
Yersinia pseudotuberculosis infection | Yersinia pseudotuberculosis |
Yersiniosis | Yersinia enterocolitica |
Yellow fever | Yellow fever virus |
Zygomycosis | Mucorales order (Mucormycosis) and Entomophthorales order (Entomophthoramycosis) |